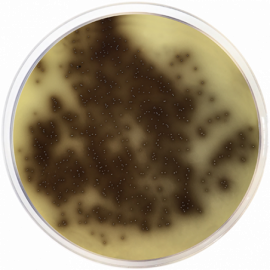
Bile Esculin Azide Agar
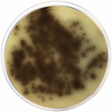

LET OP: de gemiddelde levertijd van dit artikel is 3 a 4 weken. Informeer naar de mogelijkheden tot voorraad houden.
Bile Esculin Azide Agar 500 grams
Gedehydrateerde Cultuur Media
-
Merk
-
Merk artikelnummer
Afbeeldingen dienen ter illustratie. Product kan afwijken van de getoonde foto.